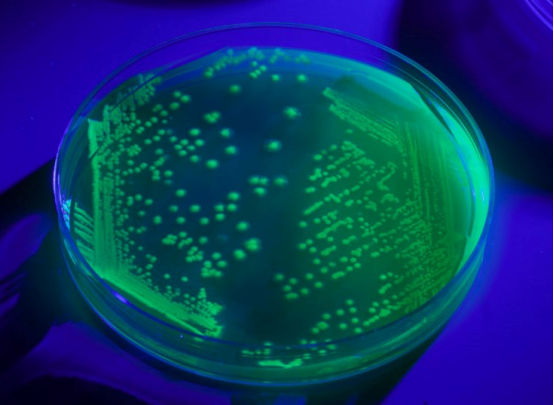
绿色荧光标记的治疗基因通过静脉注射进入大脑

杨冰
阅读量:634
“妈妈,我能自己拿勺子了吗?”在北京儿童医院康复科,4岁的朵朵颤抖着握住儿童餐具,这个普通孩子轻而易举的动作,却让在场医护人员瞬间红了眼眶。作为脊髓性肌萎缩症(SMA)Ⅲ型患者,朵朵经历了三年多的呼吸机依赖和全身肌肉萎缩,而即将在我国上市的基因替代疗法,正在改写这个家庭的命运轨迹。

在上海市儿童医学中心遗传科,每周都会新增2-3例SMA确诊患儿。这种被称为"婴幼儿头号遗传病杀手"的疾病,源于SMN1基因的突变或缺失。患者运动神经元持续退化,轻则丧失行走能力,重则吞咽呼吸功能衰竭。
令人震惊的数据显示:
· 我国SMA携带者比例高达1/50
· 每年新增患者约1200例
· Ⅰ型患儿2岁前死亡率超过90%
"很多家长优先次听到诊断时,整个人都是懵的。"北京协和医院神经内科主任医师李延峰教授回忆,有位父亲抱着6个月大的患儿在诊室呆坐三小时,反复念叨:"昨天还能踢腿的啊..."
2023年12月,国家药监局正式批准Zolgensma®在我国上市。这款定价千万级的基因疗法,采用革命性的AAV9病毒载体技术,其突破性体现在:
1. 精准定位:病毒载体可穿透血脑屏障,直达中枢神经系统
2. 长期修复:将功能性SMN1基因整合到运动神经元细胞核
3. 一次治愈:静脉注射72小时内完成基因替换工程
"就像给电脑重装系统。"参与临床试验的华山医院王伟明教授比喻,"传统药物是不断打补丁,而基因疗法是从根源改写程序。"

在浙江大学医学院附属儿童医院的临床试验中,12名接受治疗的SMA患儿呈现惊人改善:
· 100%实现无创呼吸机脱机
· 83%的患者运动功能评分提升≥3级
· 最早治疗的患儿已持续保持运动能力5年
"晨晨治疗前连抬头都困难,现在能自己穿衣服了。"杭州妈妈林女士展示着手机视频,画面里7岁男孩正在康复器械上练习踏步。这个曾被认为活不过2岁的孩子,如今向着小学入学目标稳步前进。
翻开北大医学部基因治疗实验室的档案柜,1999年的实验记录赫然在目。当时的研究团队可能不会想到,他们发现的SMN2基因调控机制,会在二十多年后成为救命关键。
· 优先代(1999-2009):完成致病基因定位与动物实验
· 第二代(2010-2019):突破病毒载体递送技术瓶颈
· 第三代(2020至今):实现工业化生产与临床转化
"每次想放弃时,就会想起病房里那些渴望的眼神。"项目元老张院士已82岁高龄,仍坚持每周参加学术研讨,"现在最紧迫的,是让更多孩子赶在运动神经元完全退化前接受治疗。"

面对1320万元的治疗定价,国家医保局火速启动专项谈判。据内部人士透露,经过11轮磋商,最终达成:
· 首年治疗费用患者自付≤50万元
· 纳入28个城市普惠型商业保险
· 国内患者援助项目提供全额援助名额
"我们已经收到300多份用药申请。"北京协和医院药学部主任透露,首批治疗将在全国15个定点医院展开,优先救治2岁以下重症患儿。
随着治疗关口不断前移,专家建议:
1. 孕前筛查:双方携带者可通过试管婴儿阻断遗传
2. 新生儿筛查:48小时内足跟血检测SMN1基因
3. 黄金治疗窗:症状前治疗有效率可达100%
4. 康复新标准:治疗后需定制神经肌肉重塑方案
上海新华医院产前诊断中心数据显示,实施孕前筛查后,高危夫妇的SMA胎儿出生率下降了92%。
【结语】"每个生命都值得全力以赴"
在深圳儿童医院基因治疗中心,墙上的世界地图标注着已救治患儿的家乡。从雪域高原到南海之滨,越来越多的坐标正在点亮。正如一位康复患儿在画作中写的:"我想跑着去见彩虹。"这或许就是医学进步最动人的模样
寻找优质医疗资源  伴您走上康复之路